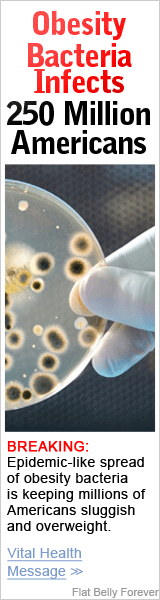

After Quarantine Weight Loss: Tips and Tricks to Look Your Best After Lockdown
Yes, email me more Tips and Tricks
Your information is protected by our Privacy Policy
Flatten Your Curves:
Losing Weight After Lockdowns
This lockdown has come with numerous curveballs, both physical and mental. Spending the majority of your time in the house, you’ve probably gained a bit of weight. It’s especially easy to gain weight for mothers forced to stay in with their children all day, overindulging in snacks, takeout, and continuously watching television.
With so many more responsibilities being in the house all day, you’re probably struggling to maintain healthy habits altogether. Thinking about how to lose weight during lockdown may cross your mind, but it may be hard to prioritize it over cleaning, homeschooling, and spending quality time as a family. Although it may seem hard to get back to your pre-quarantine body, you can lose weight in the comfort of your home. Here are some tips to lose lockdown weight and enjoy your body again.
Yes, email me more Tips and Tricks
Here are some practical post lockdown weight loss tips...
1. Adopt healthier eating habits.
One of the easiest ways to get ahead of lockdown weight loss is to eat healthier. Sitting on the couch watching Netflix usually involves eating junk food and ordering fast food from a delivery app. If you’re trying to lose weight, try going on a diet. You can still eat snacks and order takeout, simply order healthier choices.
Cut back on unhealthy snacks.
Eating salty and sweet snacks are okay every once in a while, but overindulgence makes it easy to pack on the pounds. When you make the right choices, snacking throughout the day makes it easier to lose weight than eating fewer heavier meals. Therefore, purchase low-calorie, low sugar snack options to enjoy between meals.
Eat metabolism-rich foods.
When you eat healthier, certain food choices increase your metabolism, making it easier to shed pounds. When you eat unhealthy foods, your metabolism slows down and it’s harder to burn calories. To speed up your metabolism, increase your protein intake. Eating more meat, fish, dairy and seeds raises your metabolism because they require more energy to burn them. The more calories you burn, the more weight you’ll lose.
Increase your water intake.
In addition to eating healthier foods, you must drink more water. Sure, it’s easier to chug a soda or enjoy a bottle of wine before bed, but water is your secret weapon to losing weight during lockdown. Oftentimes, your presumed hunger is actually your body craving fluids to avoid dehydration. When you drink enough water, you also suppress your appetite.
Another benefit of drinking water is that it doesn’t contain any calories. Once you drink water, it flushes the toxins from your body through urination. Between eating less food and cleansing your system, you’re bound to lose weight drinking more water. You can even add fruits and spices to the water to enhance the flavor and benefits.
Supplements
Dietary supplements don't get enough credit. From meal replacement shakes to pills, supplements provide an additional calorie burning boost. In addition to helping you lose weight, you'll also be able to make up for nutrients you aren't getting in your diet. Be sure to choose a quality supplement to avoid side effects.
2. Regulate your stress levels and sleep cycle.
Many women either don’t know or underestimate the correlation between sleep and weight gain. When you’re tired, you’re less likely to make wellness decisions like working out or planning a healthy meal. When you get enough rest, your hormones are properly regulated. This includes the hormones responsible for hunger.
The same applies with stress. When you manage your stress levels, it’s easier for you to lose weight. Otherwise, you’ll sleep less, eat more, and gain more weight.
3. Get your body moving.
An important part of getting in shape is physical activity. There are endless workout possibilities to lose lockdown weight, both in your home and outdoors. One of the greatest benefits of working out at home is you can get the entire family involved.
When it comes to physical activity, you don’t have to spend hours at a time working out to lose weight. In fact, you can spend 15 minutes a day exercising and begin seeing results. Whether you do the same exercise or prefer switching it up, here’s a list of activities to help you lose weight.
Walking
Many of us women underestimate the benefits of walking. One of the greatest reasons to start walking is it isn’t an overwhelming form of exercise. You can walk around the block or even up and down your stairs. As long as you walk for fifteen minutes twice a day, you’re bound to see results.
Interval Training
High-intensity interval training, commonly referred to as HIIT, is a great way to lose weight. HIIT workouts are great because they burn more calories in a shorter period of time. Not only does HIIT effectively burn belly fat, it also minimizes your chances of getting diseases associated with excess belly weight.
Common HIIT exercises include cycling, jumping, and running. An example of interval training is cycling really fast for 30 seconds to a minute and then pedaling slow for thirty seconds. Repeat this process for between ten and thirty minutes per workout.
Yoga
In addition to physical health, yoga is great for regulating stress levels, This allows you to lose weight. Doing a variety of yoga poses allows you to burn calories, which is great for weight loss. It also teaches you to make mindful decisions. Mindful habits minimize your chances of overeating, overindulging in unhealthy cravings, and helps you learn when your body is truly hungry.
With most yoga studios closed during quarantine, you can still practice yoga at home. Several websites offer online instructional videos. Best of all, you can practice yoga as a family.
Things to Consider
If you don’t immediately see results, there are some potential hindering factors. For example, some women struggle to lose weight based on genetics. It’s also more difficult for women to lose weight than men. This occurs based on women’s higher fat to muscle ratio.
If you’re older, it’ll take longer for you to see results. As you age, you gradually lose muscle mass. Additional factors like medical conditions and starting weight also impact your weight loss success.
If you have a genetic predisposition to weight gain or are up in age, don’t feel discouraged. Although it may be a bit more difficult, you can still lose weight. If you want a bit more encouragement, ask your family and friends to join in on your weight loss journey. Even if they don’t want to lose weight, they can help hold you accountable when you go off course. They’re also more likely to practice healthier habits while you’re around to minimize temptation.
If you want to know how to lose weight after lockdown, you need a balance of sleep, proper eating habits, and exercising. Avoid trying to lose weight too quickly. Doing so leads to adverse side effects including muscle loss, malnutrition, hair loss, and even irregular periods. You’re also more likely to gain the weight back. If you begin experiencing any of these complications, seek professional healthcare immediately.

Home
Blog
About Us
Contact
About Belly Fixx Blog
Lifestyle, health, wellness, and so much more. At Belly Fixx we write to help you. Sign up below to receive the secret morning habit that melt's fat away!
* All information is processed and kept confidential